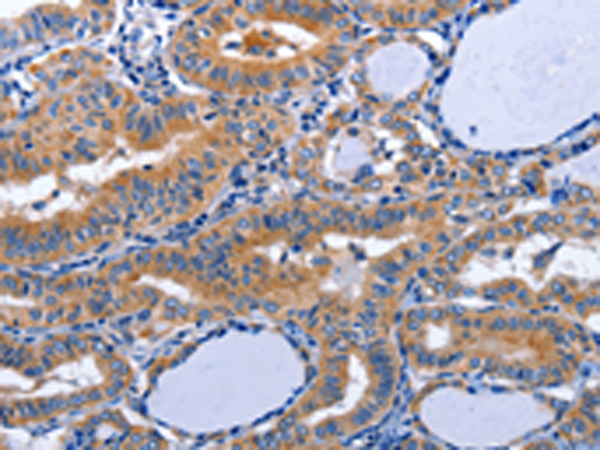

-
分类: 科研抗体货号: P10793别名: BLR1; CD185; MDR15应用: IHC反应种属: Human
-
分类: 科研抗体货号: P10773别名: DRP1, DRP-1, CRMP-1, DPYSL1, ULIP-3应用: WB,IHC反应种属: Human, Mouse, Rat
-
分类: 科研抗体货号: P10755别名: CK5, K5, DDD, EBS2, KRT5A应用: IHC反应种属: Human, Rat
-
分类: 科研抗体货号: P10792别名: C-C; CD128; CD181; CKR-1; IL8R1; IL8RA; CMKAR1; IL8RBA; CDw128a; C-C-CKR-1应用: WB反应种属: Human
-
分类: 科研抗体货号: P10772别名: DRP2, N2A3, CRMP2, DRP-2, ULIP2, CRMP-2, DHPRP2, ULIP-2应用: IHC反应种属: Human, Mouse, Rat
-
分类: 科研抗体货号: P10753别名: AP-1应用: IHC反应种属: Human, Mouse, Rat
-
分类: 科研抗体货号: P10791别名: CD182; IL8R2; IL8RA; IL8RB; CMKAR2; CDw128b应用: WB反应种属: Human
-
分类: 科研抗体货号: P10771别名: ICH; HANAC; POREN1; arresten应用: IHC反应种属: Human, Mouse
-
分类: 科研抗体货号: P10750别名: SCG1应用: IHC反应种属: Human, Mouse, Rat
-
分类: 科研抗体货号: P10790别名: AQP-8应用: IHC反应种属: Human

鄂公网安备42018502007531号
鄂公网安备42018502007531号

